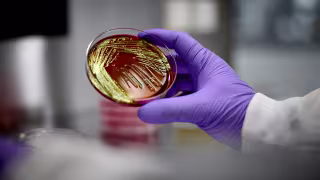

Roche Advances Trontinemab and pTau217 Blood Test in Strategic Alzheimer’s Research Push
SHERIDAN, WYOMING – July 29, 2025 – Roche is accelerating its multi-modal approach to Alzheimer’s disease, unveiling new data at the Alzheimer’s Association International Conference (AAIC) that spotlight the therapeutic potential of trontinemab and the diagnostic promise of its Elecsys® pTau217 blood test. Together, these innovations signal a possible shift toward earlier, more accessible, and more precise detection and treatment of the world’s most prevalent neurodegenerative disease.
Trontinemab shows rapid amyloid clearance with low ARIA risk